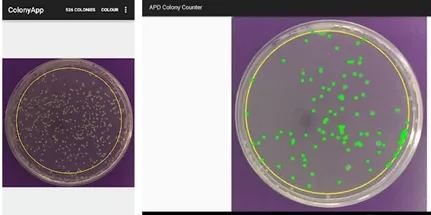

海博微信公众号
海博微信公众号
 海博天猫旗舰店
海博天猫旗舰店


 海博微信公众号
海博微信公众号
 海博天猫旗舰店
海博天猫旗舰店




在做各种样品(药品、医疗器械、化妆品、保健食品)的微生物检验中,经常会看到质量标准中会涉及CFU/g或CFU/ml。还有一些标准中单位是个/g或者个/ml。这些到底有什么差别,我们要从CFU的基本定义开始。
CFU:A colony-forming unit(CFU,cfu,CFu)is a unit used in microbiology to estimate the number of viable bacteria or fungal cells in a sample.
翻译过来就是:菌落形成单位是指微生物学中用于估算样品中活的细菌或者真菌数量的单位。
直观来说,小小的一个微生物不是肉眼可见的,必须借助高倍显微镜甚至染色后才能清楚观察到。CFU是通过平板培养基上肉眼可见的菌落数来反推样品中微生物数量的一种方式,这期间发生了分散、稀释、培养等等过程。
首先,CFU是菌落形成单位,数据不是直接反映样品中的微生物数量。是一种认可的估算。估算成功的前提是平板涂布或者接种之前微生物活细胞分散均匀。而一些链球菌、球菌等天生就不能单细胞分散均匀。另外一个因素是稀释倍数合理,有些样品的微生物含量很高,要想计数必须梯度稀释很多次,最后CFU区间落在30-300之间最为有效。太多太少都不合适。
其次,能够在平板上生长出来的活的微生物才会形成CFU。理论上,分散均匀的情况下,一个活细胞形成1CFU。在实际操作中,涡旋振荡进行混匀就会出现很多情况。微生物是分散程度更好了,但是有一些被振死了。
另外,微生物最终能在平板培养基上形成菌落还与培养基类型、培养温度及时间、接种方式、潜在微生物类型有关系。
总而言之,CFU是一种估算方法。当出现CFU时,就代表了已经选择了这种估算方式,不同的单位(如下图所示)也代表了过程的前后。

最后,来说说CFU的现实意义。举例来说,定量菌种的菌种数量如果标示的是“CFU”,也就代表这种定量菌种也是用培养基法来计数的。如果定量菌种是用流式细胞仪等其他方式计数,标示“个”更为合理。
菌落计数不一定需要专业设备,如果你的手机支持Google Play的话,可以下载APD Colony Counter App专业版,手机拍照就可以实现拍照计数,界面如下图。
本文转载自微信公众号石决明。
上一篇:食品安全标准中克罗诺杆菌属解读



